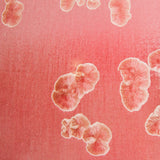

Ted Secombe
Ted Secombe — Large Crystalline Glaze Pot in Red
After 4 decades at his potter’s wheel, Ted Secombe says that making pots is more challenging now than when he first began, as his motivation is the purely the expression of his ideas and creativity. He has now developed a mastery of the medium that allows him to take his experimentation further than ever before.
Ted likes to work with different shapes and now prefers much simpler forms, forms with the sense of an easy curve, ‘like a brush stroke’. ‘My inspiration comes when the clay is on the wheel and I am looking at the sensuousness of the curve,’ he says. Sometimes he is influenced by the structure of plants and leaves. Ted’s other passion is gardening, and he has created a glorious garden around his studio.
Ted Secombe is well known for his beautiful crystalline glazes, as well as his pots of cobalt blue and deep crimson. He works with a huge range of colours and, as with his forms, Ted is always experimenting and developing new ranges of glazes, some of which are reminiscent of ancient Chinese glazes. The glazes involve different firing procedures as Ted is always attempting to achieve the best possible results by altering time, temperatures and heating rates to his firings.
—
Materials: crystalline glazed ceramic
Dimensions: approx. 50cm x 38cm